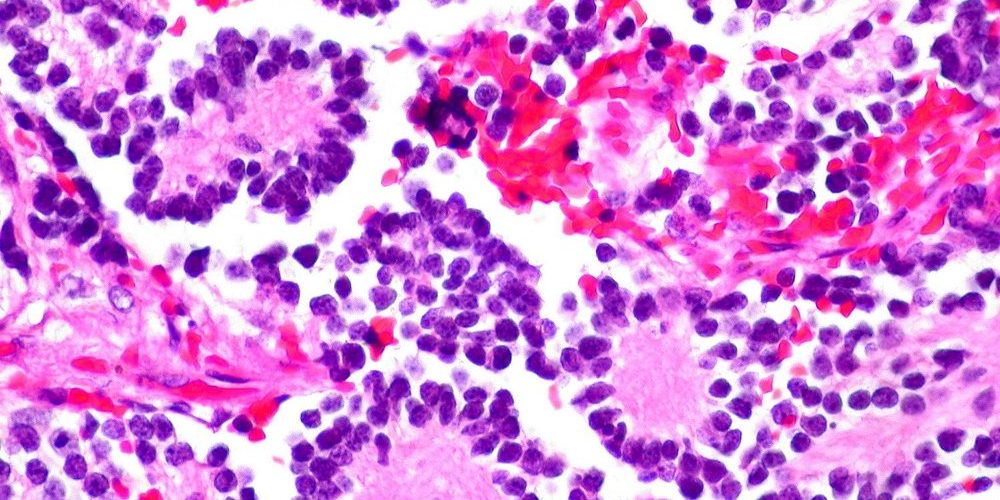

Результаты доклинического исследования, опубликованные в журнале Proceedings of the National Academy of Sciences, показывают, что комбинация двух существующих лекарств может использовать метаболический «голод» особенно агрессивного типа нейробластомы для уничтожения раковых клеток без причинения большого побочного ущерба здоровой ткани.
В то время как медицинские достижения привели к высоким показателям излечения рака крови у детей, оказалось, что нейробластому гораздо сложнее лечить, в основном из-за того, что на ген, связанный с этим раком, сложно нацелиться.
«MYCN – это фактор транскрипции, и факторы транскрипции очень сложно обработать лекарствами», — рассказывает старший автор исследования Энтони Фабер. «Следующая лучшая вещь – это нацеливаться на то, что MYCN делает в клетке».
Исследователи проверили 20 комбинаций метаболических препаратов на раковых клетках, взятых от почти 1000 различных пациентов, и обнаружили, что нейробластома с высокой экспрессией MYCN была особенно чувствительна к коктейлю, содержащему два препарата: фенформин и AZD3965.
Фенформин блокирует комплекс I на поверхности митохондрий, он был разработан в 1957 году для лечения диабета. AZD3965, гораздо более новый тип препарата, который блокирует реакторы MCT1 на поверхности клеток. На данный момент он проходит фазу I клинических исследований.
материал med2.ru